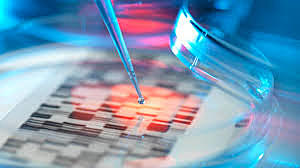
Gene Editing

-
The inventor of this new technology is Yoshizumi Ishino. He went to a school called Osaka University in Japan. The invention is called CRISPR. This invention is able to let the scientist make changes to a being’s DNA. This new technology is affecting the medical field because now the doctors can prevent a baby to have any type of genetic disease it may also help deal with complex diseases.
-
A man known as Sovaldi invented the cure for Hepatitis C. The name of this pill is Sofosbuvir but it use to be an injection but that gave a lot of side effects to the ones who took it. The pill makes you get rid of hepatitis. This good for us because then less people die because of this illness
-
This medication is called AIDS cocktail and it was made by HAART. This medicine helps you deal with AIDS and helps your body the production of the virus. This saves a lot of lives and lets people live their live normally
-
William B. Coley was the first to attempt to use this therapy. The name of this therapy for cancer treatment is called biologic therapy. This therapy helps raise the body’s natural defenses to get rid of the cancer. This helps people fight off the cancer virus.
-
A man named William Kouwenhoven is the inventor of the AED. This device is called Automatic External Defibrillator. It is a portable device that diagnoses if someone is still alive or not in a life threating situation. Making it be in public places helps a lot because it helps if someone is having a heart attack or just cant breath.
-
An American company named Intititive Surgical made up ‘The Da Vinci Surgical System’. This system is a robotic surgical system that helps doctors do complex surgeries. This machine is just using a small camera and it is controlled by a console. This system helps doctors a lot because it lets them see places then would not be able to see without hurting the patient.
-
Nazi Germany were the first to ever come up with these laws. These laws are called anti-smoking laws. They banned people from smoking in public places. They used to let people smoke where ever and that caused people go get very sick with the smoke. These laws helped because now less people get asthma or any lung problem.
-
This device was invented by Tony “Tempt” Quan. The named of the device is called EyeWriter. This device is an eye tracking system that helps people who have limited mobility draw with their eyes. This invention helps many people do what they love every day.
-
This invention was created by a man named Michael K. O’Connor. The technique is known as Miraluma. It helps detect breast cancer and lets you see where the cancer is located. This method helps doctors detect the cancer before it get worst.
-
The first creator of the artificial pancreas was a lady named Dana Lewis. This invention is called Artificial Pancreas Device System. It uses technology made by hand match the way a real pancreas works. It is used to release insulin to help with blood levels like a real pancreas would. This helps the medical field by helping individuals with Type 1 Diabetes.
Plan projects on a visual timeline
Map milestones, phases, deadlines, and key events in one place so the sequence is easier to see and share. Timetoast is a timeline maker for work, school, research, and stories.